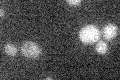

View description
Endonuclease that processes hairpin DNA structures with the MRX complex; involved in meiotic and mitotic double-strand break repair; phosphorylated in response to DNA damage and required for normal resistance to DNA-damaging agents
Localization:
Intensity:
Fold change:
Significance:
-
C’ GFP library in SD

cytosol17.95 -
N' NOP1pr-GFP in SD

nucleus58.5666 -
N' TEF2pr-mCherry in SD

nucleus,nucleolus66.7677 -
N' NATIVEpr-GFP in SD

below threshold19.4603 -
N' TEF2pr-VC and Cyto-VN in SD

nucleus31.2922 -
C’ GFP library in SD+DTT

cytosol16.220.9No -
C’ GFP library in SD+H2O2

cytosol16.540.92No -
C’ GFP library in Starvation Media
cytosol19.231.07No -
C’ GFP library on the background of Pup2-DaMP

cytosol -
C’ GFP library on the background of CCT mutant

cytosol18.51861.03098No
